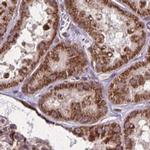
NFS1 Antibody in Immunohistochemistry (IHC)

Search
Invitrogen
NFS1 Polyclonal Antibody
{{$productOrderCtrl.translations['antibody.pdp.commerceCard.promotion.promotions']}}
{{$productOrderCtrl.translations['antibody.pdp.commerceCard.promotion.viewpromo']}}
{{$productOrderCtrl.translations['antibody.pdp.commerceCard.promotion.promocode']}}: {{promo.promoCode}} {{promo.promoTitle}} {{promo.promoDescription}}. {{$productOrderCtrl.translations['antibody.pdp.commerceCard.promotion.learnmore']}}
产品信息
PA5-63017
种属反应
宿主/亚型
分类
类型
抗原
偶联物
形式
浓度
规格
纯化类型
保存液
内含物
保存条件
运输条件
RRID
产品详细信息
Immunogen sequence: SNNIAIKGVA RFYRSRKKHL ITTQTEHKCV LDSCRSLEAE GFQVTYLPVQ KSGIIDLKEL EAAIQPDTSL VSVMTVNNEI GVKQPIAEIG RICSSRKV
Highest antigen sequence identity to the following orthologs: Mouse - 97%, Rat - 96%.
靶标信息
NFS1 (nitrogen fixation 1), also known as NIFS or IscS (cysteine desulfurase), is a member of the class V pyridoxal-phosphate-dependent aminotransferase family. It localizes to the cytoplasm or mitochondrion depending on which form is generated based on cytosolic pH. Highest expression levels of NFS1 are found in heart and skeletal muscle. Lower levels of expression are also found in liver, brain and pancreas. NFS1 is responsible for catalyzing the removal of sulfur from cysteine to form alanine, thereby supplying the inorganic sulfur for iron-sulfur (Fe-S) clusters. Fe-S clusters function as essential cofactors in a wide variety of events, including facilitation of electron transfer processes in oxidative phosphorylation, catalysis of enzymatic reactions in aconitase and dehydratases and maintenance of structural integrity in the DNA repair enzyme endonuclease III.
仅用于科研。不用于诊断过程。未经明确授权不得转售。
篇参考文献 (0)
生物信息学
蛋白别名: Cysteine desulfurase; cysteine desulfurase, mitochondrial; NFS1 nitrogen fixation 1 homolog; nitrogen fixation 1 (S. cerevisiae, homolog); nitrogen-fixing bacteria S-like protein; similar to Azotobacter vinelandii nifS; unnamed protein product
基因别名: COXPD52; HUSSY-08; IscS; NFS1; NIFS
UniProt ID: (Human) Q9Y697
Entrez Gene ID: (Human) 9054